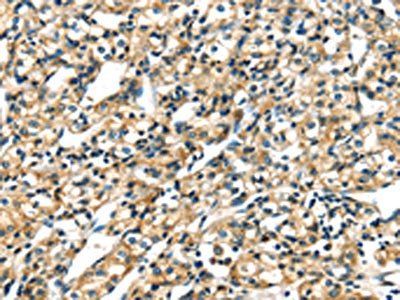
KRT17 Antibody

You have no items in your shopping cart.
Description
Images & Validation
−
| Application Notes |
|---|
Key Properties
−| Source | Escherichia Coli |
|---|---|
| Purity | Greater than 90% as determined by SDS-PAGE. |
| Protein Sequence | MGSSHHHHHH SSGLVPRGSH MGSMTTSIRQ FTSSSSIKGS SGLGGGSSRT SCRLSGGLGA GSCRLGSAGG LGSTLGGSSY SSCYSFGSGG GYGSSFGGVD GLLAGGEKAT MQNLNDRLAS YLDKVRALEE ANTELEVKIR DWYQRQAPGP ARDYSQYYRT IEELQNKILT ATVDNANILL QIDNARLAAD DFRTKFETEQ ALRLSVEADI NGLRRVLDEL TLARADLEMQ IENLKEELAY LKKNHEEEMN ALRGQVGGEI NVEMDAAPGV DLSRILNEMR DQYEKMAEKN RKDAEDWFFS KTEELNREVA TNSELVQSGK SEISELRRTM QALEIELQSQ LSMKASLEGN LAETENRYCV QLSQIQGLIG SVEEQLAQLR CEMEQQNQEY KILLDVKTRL EQEIATYRRL LEGEDAHLTQ YKKEPVTTRQ VRTIVEEVQD GKVISSREQV HQTTR |
Storage & Handling
−| Storage | Stability: Store at 4°C if entire vial will be used within 2-4 weeks. Store, frozen at -20°C for longer periods of time.For long term storage it is recommended to add a carrier protein (0.1% HSA or BSA).Please avoid freeze thaw cycles |
|---|---|
| Form/Appearance | Sterile Filtered clear solution. |
| Buffer/Preservatives | KRT17 protein solution (0.5mg/ml) containing 20mM Tris-HCl buffer (pH8.0), 10% glycerol and 0.4M Urea. |
| Expiration Date | 6 months from date of receipt. |
| Disclaimer | For research use only |
Alternative Names
−Similar Products
−Recombinant Human KRT17 Protein, N-His [orb2968113]
ELISA, SDS-PAGE, WB
>90% as determined by SDS-PAGE.
18.89 kDa
1 mg, 50 μg, 100 μgRecombinant Human KRT17 Protein, N-His [orb3148997]
ELISA, SDS-PAGE, WB
>90% as determined by SDS-PAGE.
42.93 kDa
50 μg, 100 μg, 1 mgRecombinant human CK17 protein, N-Trx-His [orb1808049]
>90% as determined by SDS-PAGE
66.1 kDa
100 μg, 500 μg, 20 μgCK17 Rabbit Polyclonal Antibody (FITC) [orb15384]
IF
Bovine, Canine, Equine, Rat, Sheep
Human, Mouse
Rabbit
Polyclonal
FITC
100 μl

Quality Guarantee
Explore bioreagents carefree to elevate your research. All our products are rigorously tested for performance. If a product does not perform as described on its datasheet, our scientific support team will provide expert troubleshooting, a prompt replacement, or a refund. For full details, please see our Terms & Conditions and Buying Guide. Contact us at [email protected].
Documents Download
Request a Document
Protocol Information
Human KRT17 Protein (orb259941)
Participating in our Biorbyt product reviews program enables you to support fellow scientists by sharing your firsthand experience with our products.
Login to Submit a Review